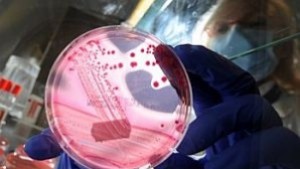
Откритие бележи стъпка напред по пътя към лечение на диабет

Технологии
Актуални новини от Технологии. Посетете нашата секция с новини от Технологии Сега!
27.09.2011
LEGO създаде Ford Explorer в реални размери
Какво може да направите за 2500 часа и с 380 000 блокчета LEGO? Да построите Ford Explorer в реални ...
27.09.2011
Откритие бележи стъпка напред по пътя към лечение на диабет
Френски учени са успели да създадат първо поколение човешки функционални бета панкреасни ...
26.09.2011
Нова концепция от Gordon Murray Design
Gordon Murray Design показа нов електрически прототип със задно предаване. Компанията, оглавена ...
26.09.2011
Печелившата комбинация
BMW и Land Rover се обединяват за рали „Дакар". Създаденият от Race Cars Rable състезателен автомобил ...
26.09.2011
Хапче ще намалява бръчките с 30%
Учени създадоха хапче, което ще намалява бръчките до 30%. Първите резултати от клиничните ...
25.09.2011
Мобифон колкото кибритена кутийка
Японската компания Willcom представи мобифона WX03A, който беше определен като най-малкия ...
24.09.2011
Американският спътник е паднал на Земята, видели отломки в Канада
НАСА потвърди, че отломки от американския сателит са паднали на Земята, но все още се ...
24.09.2011
Американският сателит е паднал на Земята, според прогнозите на НАСА
Шесттонният научен спътник на САЩ е навлязъл в плътните слоеве на земната атмосфера, ...
23.09.2011
Американски сателит пада към Земята, съобщава НАСА
Американски сателит с големината на микробус се очаква да падне днес на Земята, съобщават ...
23.09.2011
Учени откриха частици, движещи се по-бързо от светлината
Международен екип от учени откри неутрини, движещи се по-бързо от скоростта на светлината, ...
21.09.2011
България е в челната тройка по скорост на сваляне от интернет
България е на трето място в света по скорост на сваляне от интернет. Пред нея се нареждат ...
21.09.2011
Русия изстреля успешно военен сателит
Русия изстреля успешно военен сателит след триседмично отлагане, причинено от повреда ...
20.09.2011
Porsche готви фейслифт на Panamera
Porsche работи върху фейслифт на Panamera. След като популярният хечбек с пет врати вече няколко ...
20.09.2011
Mercedes ще произвежда SLS AMG Black Series
След години спекулации Mercedes потвърди плановете си за производство на SLS AMG Black Series. Шефът ...
20.09.2011
Бъдещи космически изследователи ще се гмуркат край Флорида
Когато астронавтите за пръв път стъпят на астероид, те ще трябва по-скоро да "плуват" ...
19.09.2011
Японски правителствени агенции станаха жертва на хакерски атаки
Уебсайтовете на няколко правителствени агенции в Япония бяха поразени от кибератаки ...
19.09.2011
Концепцията на Peugeot върви с чифт обувки
Това е концепцията Peugeot HX1, създадена с помощта на дизайнера на обувки Пиер Арди. Любопитното ...
19.09.2011
Удвояват производството на Renault Megane R.S Trophy `
Времето, регистрирано от Renault Megane R.S Trophy на „Нюрбургринг", вероятно е засилило интереса ...
19.09.2011
"Липсващото" глобално затопляне може би се крие в океаните
Мистерията за липсващата топлина на Земята е разрешена: тя може би се спотайва дълбоко ...
16.09.2011
Ferrari Spider 458 Italia направи световния си дебют
Състоя се световният дебют на новия вариант Spider 458 Italia във Франкфурт. Суперспортният ...
16.09.2011
Нобелист оспорва вината на човека за затоплянето на климата
Норвежецът Ивар Йевер, носител на Нобелова награда за физика, напусна Американското ...
16.09.2011
"Съюз ТМА-21" се приземи успешно на територията на Казахстан
Спускаемият апарат на космическия кораб "Съюз ТМА-21" с трима космонавти от Международната ...
16.09.2011
Еволюиралото Porsche 911 разкрито
Новото Porsche 911 с еволюционен дизайн веднага бе разпознато на щанда на марката във Франкфурт. ...
15.09.2011
Откриха планета с две слънца
Астрономи са открили планета, която обикаля около две звезди - подобно на измислената ...
15.09.2011
ООН: Един на осем души може да влезе в интернет където и когато пожелае
Един на всеки осем души по света може да влезе в интернет където и когато пожелае, сочи ...
15.09.2011
"Еврейското" приложение на Apple, предизвикало скандал във Франция, се изтегля от пазара
Американският компютърен гигант Apple обяви, че изтегля от продажба във Франция приложение ...
15.09.2011
Facebook пуска нова функция Subscribe
Социалната мрежа Facebook пуска нова функция Subscribe, с помощта, на която потребителите ще ...
14.09.2011
„Безопасност на храните” е темата на тазгодишното международно състезание по роботика
„Безопасност на храните" е темата на тазгодишното международно състезание по роботика ...
14.09.2011
Facebook назначи отговорник по защитата на личните данни
Facebook обяви, че е назначил отговорник за защитата на личните данни на потребителите ...
13.09.2011
Smart Computing може да помогне на правителства и бизнеса да постигат повече с по-малко
Интервю с Пабло Рама, Вицепрезидент, Systems and Technology Group, IBM Централна и Източна Европа
Какво ...
13.09.2011
България е в челната петица на най-влиятелните държави онлайн
Над 1300 човека от 76 държави спорят за престижното отличие на Webit Influence
Конкурс на Webit ...
13.09.2011
Най-екстремният бик показа рога
Щефан Винкелман, президент и председател на Automobili Lamborghini S.p.A., представи най-мощното ...
13.09.2011
Изненадата на Fisker е шутинг брейк
Fisker показа нов шутинг брейк във Франкфурт. Въпреки приликите с Ferrari FF, Surf shooting идва с ...
13.09.2011
Откриха още една годна за живот планета
Астрономи откриха отвъд пределите на Слънчевата система планета, на която потенциално ...
12.09.2011
Фейслифтът на BMW X6 с три турбокомпресора
Заснеха фейслифт на BMW X6 по време на тестове в Европа. Промените в модела включват нова ...
12.09.2011
Insignia 2012 изкушава с обновени двигатели и повече комфорт
Insignia 2012 изкушава с нов бензинов 1,4-литров турбодвигател, който е най-икономичен в класа ...
12.09.2011
Руски астроном-любител откри нова комета
Астрономът-любител Артьом Новичонок, студент от Петрозаводския университет, е първооткривател ...
11.09.2011
За полет до Марс ще са нужни „усъвършенствани” космонавти
Ще се наложи на космонавтите, които ще се отправят към Марс, да се премахнат или заменят ...
10.09.2011
НАСА изстреля към Луната сондите си GRAIL
НАСА изстреля от Кейп Канаверал двете си сонди за изучаване на Луната - GRAIL-A и GRAIL-B, предаде ...
09.09.2011
Twitter няма да бърза с IPO
Компанията Twitter Inc., собственик на едноименния сайт за микроблогове, не бърза да проведе ...